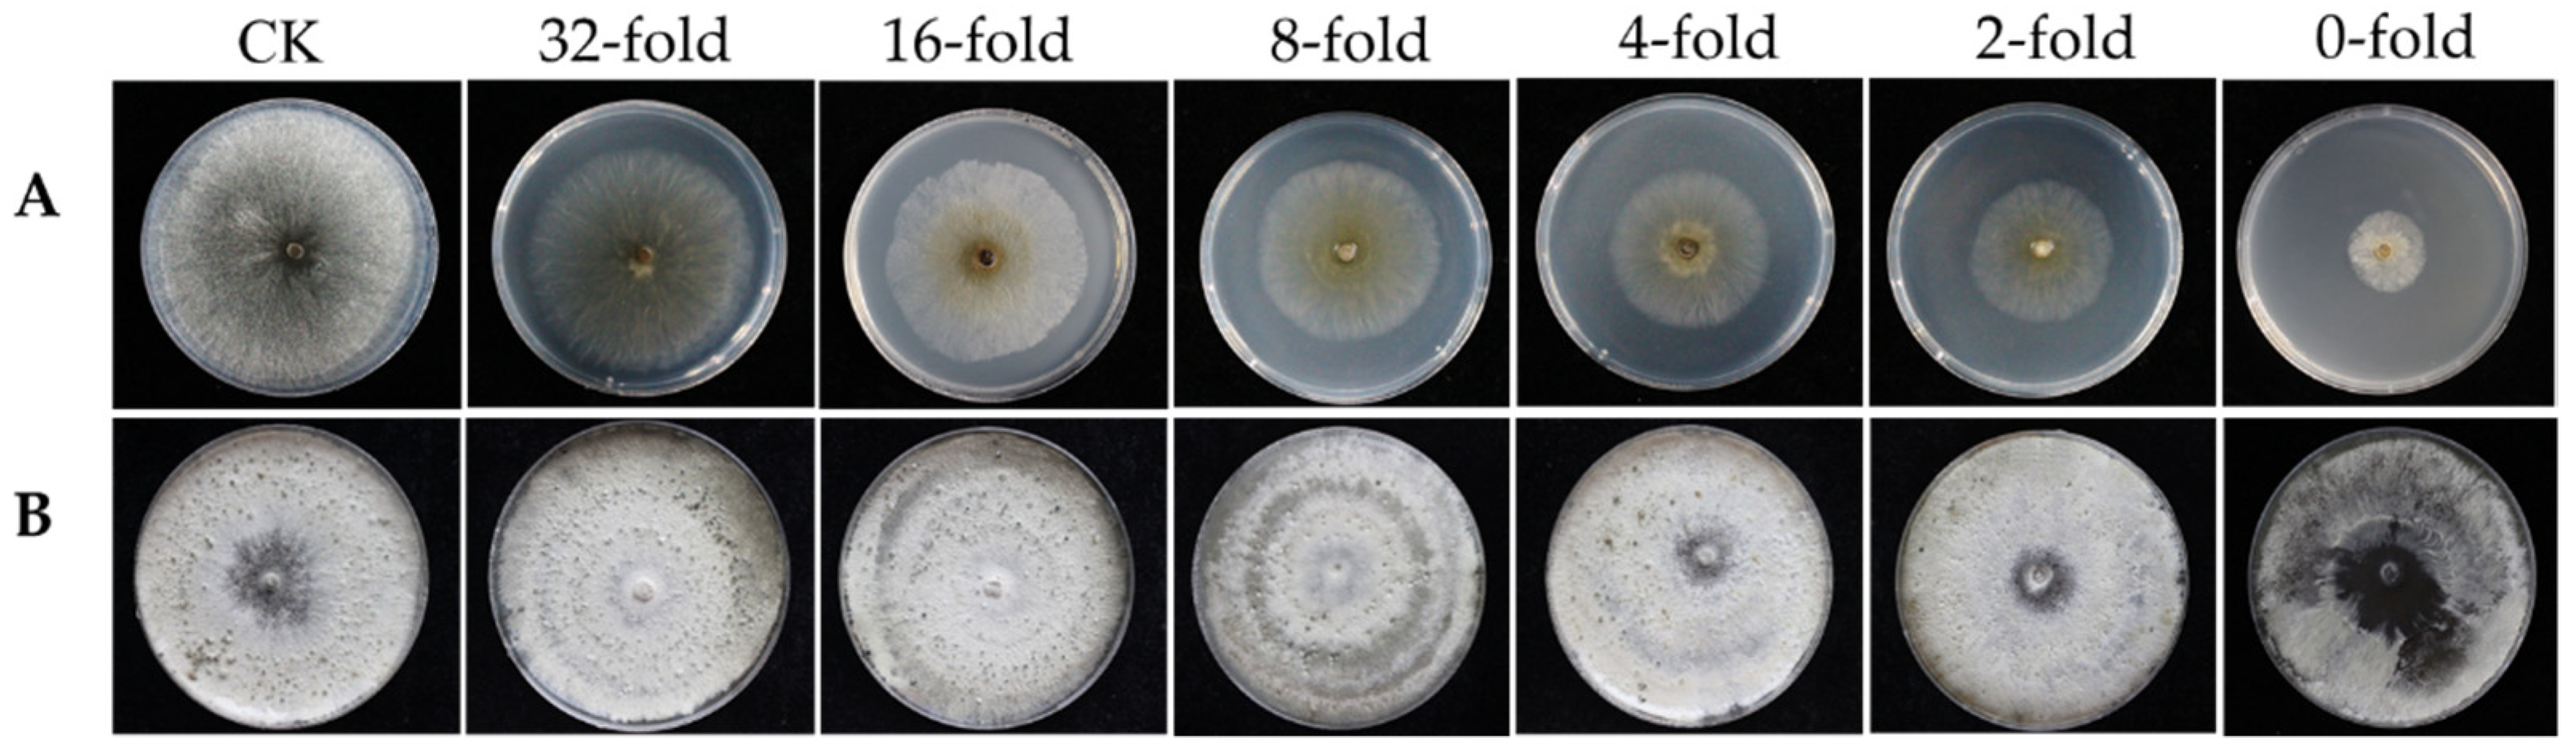
Jof 08 00113 g001

Mechanisms of Trichoderma longibrachiatum T6 Fermentation against Valsa mali through Inhibiting Its Growth and Reproduction, Pathogenicity and Gene Expression
Abstract
:1. Introduction
2. Materials and Methods
2.1. Preparation of Pathogen and Antagonistic Strain
2.2. Preparation of T6 Fermentation
2.3. Determination of Antifungal Activity of T6 Fermentation
2.4. Examination of Conidia Germination and Mycelial Growth of V. mali
2.5. Determination of the Pathogenicity of V. mali on Detached Twig Branches
2.6. Assay of the Cell Wall-Degrading Enzyme Activity of V. mali
2.7. Measurement of Gene Expression in V. mali before and after T6 Fermentation Treatment
3. Results
3.1. Inhibition of Colony Growth and Pycnidial Formation of V. mali by T6 Fermentation
3.2. Inhibitory Effect of T6 Fermentation on the Mycelial Growth and Morphological Characters of V. mali
3.3. Inhibition of Conidia Germination of V. mali by T6 Fermentation
3.4. Effect of T6 Fermentation on Lesion Development in Detached Twigs
3.5. Cell Wall-Degrading Enzyme Activity of V. mali after T6 Fermentation Treatments
3.6. Expression of Genes of V. mali after T6 Fermentation Treatments
4. Discussion
5. Conclusions
Supplementary Materials
Author Contributions
Funding
Institutional Review Board Statement
Informed Consent Statement
Data Availability Statement
Conflicts of Interest
References
- Wang, X.L.; Wei, J.L.; Huang, L.L.; Kang, Z.S. Re-evaluation of pathogens causing Valsa canker on apple in China. Mycologia 2011, 103, 317–324. [Google Scholar] [CrossRef]
- Vasilyeva, L.; Kim, W.G. Valsa mali miyabe et yamada, the causal fungus of apple tree canker in East Asia. Mycobiology 2000, 28, 153–157. [Google Scholar] [CrossRef] [Green Version]
- Abe, K.; Kotoda, N.; Kato, H.; Soejima, J. Genetic studies on resistance to Valsa canker in apple: Genetic variance and breeding values estimated from intra- and inter-specific hybrid progeny populations. Tree Genet. Genomes 2011, 7, 363–372. [Google Scholar] [CrossRef]
- Lee, D.H.; Lee, S.W.; Choi, K.H.; Kim, D.A.; Uhm, J.Y. Survey on the occurrence of apple diseases in Korea from 1992 to 2000. Plant Pathol. J. 2006, 22, 375–380. [Google Scholar] [CrossRef]
- Wang, S.T.; Hu, T.L.; Wang, Y.N.; Luo, Y.; Michailides, T.J.; Cao, K.Q. New understanding on infection processes of Valsa canker of apple in China. Eur. J. Plant Pathol. 2016, 146, 531–540. [Google Scholar] [CrossRef]
- Wang, X.L.; Zang, R.; Yin, Z.Y.; Kang, Z.S.; Huang, L.L. Delimiting cryptic pathogen species causing apple Valsa canker with multilocus data. Ecol. Evol. 2014, 4, 1369–1380. [Google Scholar] [CrossRef]
- Li, B.H.; Wang, C.X.; Dong, X.L. Research progress in apple diseases and problems in the disease management in China. Plant Protect. 2013, 39, 46–54. [Google Scholar] [CrossRef]
- Lei, P.; Xu, Y.; Du, J.; Yang, X.L.; Yuan, H.Z.; Xu, G.F.; Ling, Y. Design, synthesis and fungicidal activity of N-substituted benzoyl-1,2,3,4-tetrahydroquinolyl-1-carboxamide. Bioorg. Med. Chem. 2016, 26, 2544–2546. [Google Scholar] [CrossRef]
- Yan, W.; Wei, P.; Wang, D.; Hao, S.H.; Li, W.W.; Ding, F. Design, synthesis, antifungal activity, and 3D-QSAR of coumarin derivatives. J. Pestic. Sci. 2018, 43, 88–95. [Google Scholar] [CrossRef] [Green Version]
- Zhang, X.B.; Lei, P.; Sun, T.D.; Jin, X.Y.; Yang, X.L.; Ling, Y. Design, synthesis, and fungicidal activity of novel thiosemicarbazide derivatives containing piperidine fragments. Molecules 2017, 22, 2085. [Google Scholar] [CrossRef] [Green Version]
- Abe, K.; Kotoda, N.; Kato, H.; Soejima, J. Resistance sources to Valsa canker (Valsa ceratosperma) in a germplasm collection of diverse Malus species. Plant Breed. 2010, 126, 449–453. [Google Scholar] [CrossRef]
- Wang, Y.; Sun, Y.; Han, L.R.; Zhang, X.; Feng, J.T. Potential use of cuminic acid as a botanical fungicide against Valsa mali. Microb. Pathog. 2017, 106, 9–15. [Google Scholar] [CrossRef] [PubMed]
- Kim, B.S.; Hwang, B.K. Microbial fungicides in the control of plant diseases. J. Phytopathol. 2007, 155, 641–653. [Google Scholar] [CrossRef]
- Yin, Z.Y.; Liu, H.Q.; Li, Z.P.; Ke, X.W.; Dou, D.L.; Gao, X.N.; Song, N.; Dai, Q.Q.; Wu, Y.X.; Xu, J.R. Genome sequence of Valsa canker pathogens uncovers a potential adaptation of colonization of woody bark. New Phytol. 2015, 208, 1202–1216. [Google Scholar] [CrossRef] [PubMed]
- Miles, L.A.; Lopera, C.A.; González, S.; García, M.C.C.D.; Franco, A.E.; Restrepo, S. Exploring the biocontrol potential of fungal endophytes from an Andean Colombian Paramo ecosystem. Biocontrol 2012, 57, 697–710. [Google Scholar] [CrossRef]
- Atanasova, L.; Crom, S.L.; Gruber, S.; Coulpier, F.; Verena, S.S.; Kubicek, C.P.; Druzhinina, I.S. Comparative transcriptomics reveals different strategies of Trichoderma mycoparasitism. BMC Genom. 2013, 14, 121. [Google Scholar] [CrossRef] [Green Version]
- Guo, R.T.; Wang, Z.Y.; Zhou, C.; Liu, Z.H.; Zhang, P.; Fan, H.J. Transcriptomic analysis reveals biocontrol mechanisms of Trichoderma harzianum ACCC30371 under eight culture conditions. J. For. Res. 2019, 31, 1863–1873. [Google Scholar] [CrossRef]
- Ahluwalia, V.; Kumar, J.; Rana, V.S.; Sati, O.P.; Walia, S. Comparative evaluation of two Trichoderma harzianum strains for major secondary metabolite production and antifungal activity. Nat. Prod. Res. 2015, 29, 914–920. [Google Scholar] [CrossRef]
- Pakora, G.-A.; Mpika, J.; Kone, D.; Ducamp, M.; Kebe, I.; Nay, B.; Buisso, D. Inhibition of Phytophthora species, agents of cocoa black pod disease, by secondary metabolites of Trichoderma species. Environ. Sci. Pollut. Res. 2018, 25, 29901–29909. [Google Scholar] [CrossRef]
- Verma, M.; Brar, S.K.; Tyagi, R.D.; Sahai, V.; Prévost, D.; Valéro, J.R.; Surampalli, R.Y. Bench-scale fermentation of Trichoderma viride on wastewater sludge: Rheology, lytic enzymes and biocontrol activity. Enzyme Microb. Technol. 2007, 41, 764–771. [Google Scholar] [CrossRef]
- Yang, X.M.; Chen, L.H.; Yong, X.Y.; Shen, Q.R. Formulations can affect rhizosphere colonization and biocontrol efficiency of Trichoderma harzianum SQR-T037 against Fusarium wilt of cucumbers. Biol. Fertil. Soils. 2011, 47, 239–248. [Google Scholar] [CrossRef]
- Zhang, S.W.; Xu, B.L.; Zhang, J.H.; Gan, Y.T. Identification of the antifungal activity of Trichoderma longibrachiatum T6 and assessment of bioactive substances in controlling phytopathgens. Pestic. Biochem. Physiol. 2018, 147, 59–66. [Google Scholar] [CrossRef] [PubMed]
- Liu, J.; Zhang, Y.; Shen, Z.Y.; Zhang, S.W.; Xue, Y.Y.; Liang, Q.L.; Tao, F.; Xu, B.L. Inhibitory effect of Trichoderma longibrachiatum T6 on Fusarium. oxysporum. Acta Agric. Boreali-Occident. Sin. 2020, 29, 1891–1897. [Google Scholar]
- Chen, X.L.; Niu, C.W.; Li, B.H.; Li, G.F.; Wang, C.X. The kinds and activities of cell wall-degrading enzymes produced by Valsa ceratosperma. Acta Agricu. Boreali-Occident. Sin. 2012, 27, 207–212. [Google Scholar] [CrossRef]
- Gairola, C.; Powell, D. Extracellular enzymes and pathogenesis by peach Cytosporas. J. Phytopathol. 1971, 72, 305–314. [Google Scholar] [CrossRef]
- Ke, X.W.; Huang, L.L.; Han, Q.M.; Gao, X.; Kang, Z.S. Histological and cytological investigations of the infection and colonization of apple bark by Valsa mali var. mali. Australas. Plant Pathol. 2013, 42, 85–93. [Google Scholar] [CrossRef]
- Ke, X.W.; Yin, Z.Y.; Song, N.; Dai, Q.Q.; Voegele, R.T.; Liu, Y.Y.; Wang, H.Y.; Gao, X.N.; Kang, Z.S.; Huang, L.L. Transcriptome profiling to identify genes involved in pathogenicity of Valsa mali on apple tree. Fungal Genet. Biol. 2014, 68, 31–38. [Google Scholar] [CrossRef]
- Song, N.; Dai, Q.Q.; Zhu, B.T.; Wu, Y.X.; Xu, M.; Voegele, R.T.; Gao, X.N.; Kang, Z.S.; Huang, L.L. Gα proteins Gvm2 and Gvm3 regulate vegetative growth, asexual development, and pathogenicityon apple in Valsa mali. PLoS ONE 2017, 12, e0173141. [Google Scholar] [CrossRef]
- Wu, Y.X.; Xu, L.S.; Yin, Z.Y.; Dai, Q.Q.; Gao, X.; Feng, H.; Voegele, R.T.; Huang, L.L. Two members of the velvet family, VmVeA and VmVelB, affect conidiation, virulence and pectinase expression in Valsa mali. Mol. Plant Pathol. 2017, 19, 1639–1651. [Google Scholar] [CrossRef] [Green Version]
- Etebarian, H.R.; Sholberg, P.L.; Eastwell, K.C.; Sayler, R.J. Biological control of apple blue mold with Pseudomonas fluorescens. Can. J. Microbiol. 2005, 51, 591–598. [Google Scholar] [CrossRef]
- Zang, R.; Huang, L.L.; Kang, Z.S.; Wang, X.L. Biological characteristics and pathogenicity of different isolates of Cytospora spp. isolated from apple trees in Shaanxi province. Acta Phytopathol. Sin. 2007, 37, 343–351. [Google Scholar] [CrossRef]
- Pietro, A.D.; Roncero, M.I.G. Endopolygalacturonase from Fusarium oxysporum f. sp. lycopersici: Purification, characterization, and production during infection of tomato plants. Phytopathology 1996, 86, 1324–1330. [Google Scholar] [CrossRef]
- Miller, G.L. Use of dinitrosalicylic acid reagent for determination of reducing sugar. Anal. Biochem. 1959, 31, 426–428. [Google Scholar] [CrossRef]
- Liu, C.; Fan, D.Y.; Li, Y.F.; Chen, Y.; Huang, L.L.; Yan, X. Transcriptome analysis of Valsa mali reveals its response mechanism to the biocontrol actinomycete Saccharothrix yanglingensis Hhs.015. BMC Microbiol. 2018, 18, 90. [Google Scholar] [CrossRef]
- Yin, Z.Y.; Ke, X.W.; Huang, D.X.; Gao, X.N.; Voegele, R.T.; Kang, Z.S.; Huang, L.L. Validation of reference genes for gene expression analysis in Valsa mali var. mali using real-time quantitative PCR. World J. Microbiol. Biotechnol. 2013, 29, 1563–1571. [Google Scholar] [CrossRef]
- Narayanasamy, P.; Thokala, P.; Muthukrishnan, S.; Kamil, D. Screening of different Trichoderma species against agriculturally important foliar plant pathogens. J. Environ. Biol. 2015, 36, 191–198. Available online: https://europepmc.org/article/MED/26536792 (accessed on 21 November 2021).
- Zhang, X.J.; Harvey, P.R.; Stummer, B.E.; Warren, R.A.; Zhang, G.Z.; Guo, K.; Li, J.S.; Yang, H.T. Antibiosis functions during interactions of Trichoderma afroharzianum and Trichoderma gamsii with plant pathogenic Rhizoctonia and Pythium. Funct. Integr. Genom. 2015, 15, 599–610. [Google Scholar] [CrossRef]
- Zhao, P.; Ren, A.; Dong, P.; Sheng, Y.; Li, D. Antimicrobial peptaibols, Trichokonins, inhibit mycelial growth and sporulation and induce cell apoptosis in the pathogenic fungus Botrytis cinerea. Appl. Biochem. Microbiol. 2018, 54, 396–403. [Google Scholar] [CrossRef]
- Zaki, S.A.; Ouf, S.A.; Albarakaty, F.M.; Habeb, M.M.; Aly, A.A.; Abd-Elsalam, K.A. Trichoderma harzianum-mediated ZnO nanoparticles: A green tool for controlling soil-borne pathogens in cotton. J. Fungi 2021, 7, 952. [Google Scholar] [CrossRef]
- Daniel, H. Antibiosis in vitro of Trichoderma strains metabolic extract on mycelial growth and reproductive capacity of Fusarium oxysporum isolated from pepper plants (Capsicum annuum L.). Br. Biotech. J. 2014, 4, 387–399. [Google Scholar] [CrossRef]
- Zhang, J.X.; Gu, Y.B.; Chi, F.M.; Ji, Z.R.; Wu, J.Y.; Dong, Q.L.; Zhou, Z.S. Bacillus amyloliquefaciens GB1 can effectively control apple valsa canker. Biol. Control 2015, 88, 1–7. [Google Scholar] [CrossRef]
- Aneja, M.; Gianfagna, T.J.; Hebbar, P.K. Trichoderma harzianum produces nonanoic acid, an inhibitor of spore germination and mycelial growth of two cacao pathogens. Physiol. Mol. Plant Pathol. 2005, 67, 304–307. [Google Scholar] [CrossRef]
- Ghasemi, S.; Safaie, N.; Shahbazi, S.; Shams-Bakhsh, M.; Askari, H. The role of cell wall degrading enzymes in antagonistic traits of Trichoderma virens against Rhizoctonia solani. Iran. J. Biotechnol. 2020, 18, e2333. [Google Scholar] [CrossRef] [PubMed]
- Javeria, S.; Kumar, A.; Kharkwal, A.C.; Varma, A.; Srinivasa, N.; Sharma, P. Evaluation of rhizospheric Trichoderma species strains for producing cell wall-degrading and defense related enzymes in response to Fusarium oxysporum f. sp. lentis. Indian Phytopathol. 2020, 73, 461–467. [Google Scholar] [CrossRef]
- Liu, R.H.; Li, J.Y.; Zhang, F.R.; Zheng, D.; Chang, Y.L.; Xu, L.S.; Huang, L.L. Biocontrol activity of Bacillus velezensis D4 against apple Valsa canker. Biol. Control 2021, 163, 104760. [Google Scholar] [CrossRef]
- Rajani, P.; Chandrasekaran, R.; Vasanthakumari, M.M.; Olsson, S.B.; Ravikanth, G.; Shaanker, R.U. Inhibition of plant pathogenic fungi by endophytic Trichoderma spp. through mycoparasitism and volatile organic compounds. Microbiol. Res. 2020, 242, 126595. [Google Scholar] [CrossRef]
- Li, Z.P.; Gao, X.N.; Fan, D.Y.; Yan, X.; Kang, Z.S.; Huang, L.L. Saccharothrix yanglingensis Strain Hhs.015 is a promising biocontrol agent on apple Valsa canker. Plant Dis. 2015, 100, 510–514. [Google Scholar] [CrossRef] [Green Version]
- Castoria, R.; De Curtis, F.; Lima, G.; Caputo, L.; Pacifico, S.; De Cicco, V. Aureobasidium pullulans (LS-30) an antagonist of postharvest pathogens of fruits: Study on its modes of action. Postharvest Biol. Technol. 2001, 22, 7–17. [Google Scholar] [CrossRef]
- Feng, Y.Q.; Yin, Z.Y.; Wu, Y.X.; Xu, L.S.; Du, H.X.; Wang, N.N.; Huang, L.L. LaeA controls virulence and secondary metabolism in apple canker pathogen Valsa mali. Front. Microbiol. 2020, 11, 2693. [Google Scholar] [CrossRef] [PubMed]
- Li, Z.P.; Yin, Z.Y.; Fan, Y.Y.; Xu, M.; Kang, Z.S.; Huang, L.L. Candidate effector proteins of the necrotrophic apple canker pathogen Valsa mali can suppress BAX-induced PCD. Front. Plant Sci. 2015, 6, 579. [Google Scholar] [CrossRef] [Green Version]
- Wu, Y.X.; Xu, L.S.; Liu, J.; Yin, Z.Y.; Gao, X.N.; Feng, H.; Huang, L.L. A mitogen-activated protein kinase gene (VmPmk1) regulates virulence and cell wall degrading enzyme expression in Valsa mali. Microb. Pathog. 2017, 111, 298–306. [Google Scholar] [CrossRef] [PubMed]
- Xu, C.J.; Wu, Y.X.; Dai, Q.Q.; Li, Z.P.; Gao, X.N.; Huang, L.L. Function of polygalacturonase genes Vmpg7 and Vmpg8 of Valsa mali. Sci. Agric. Sin. 2016, 8, 1489–1498. [Google Scholar] [CrossRef]
- Xu, M.; Guo, Y.; Tian, R.Z.; Gao, C.; Guo, F.R.; Voegele, R.T.; Bao, J.Y.; Li, C.J.; Jia, C.H.; Feng, H.; et al. Adaptive regulation of virulence genes by microRNA-like RNAs in Valsa mali. New Phytol. 2020, 227, 899–913. [Google Scholar] [CrossRef] [PubMed]
- Halifu, S.; Deng, X.; Song, X.S.; Song, R.Q.; Liang, X. Inhibitory mechanism of Trichoderma virens ZT05 on Rhizoctonia solani. Plants 2020, 9, 912. [Google Scholar] [CrossRef]

| Dilutions (Folds) | Colony Diameters (cm) | Inhibitory Rates (%) | Pycnidia Amounts (Pycnidia per Media) |
|---|---|---|---|
| 0 | 1.93 | 94.86 ± 0.47 a | 0.00 ± 0.00 g |
| 2 | 2.73 | 89.63 ± 1.19 b | 22.67 ± 4.93 f |
| 4 | 4.17 | 75.97 ± 0.70 c | 41.17 ± 4.02 e |
| 8 | 4.67 | 69.85 ± 0.98 d | 59.50 ± 6.09 d |
| 16 | 5.61 | 56.46 ± 1.42 e | 125.00 ± 9.38 c |
| 32 | 6.64 | 38.91 ± 3.26 f | 157.50 ± 6.63 b |
| ck | 8.50 | — | 227.83 ± 12.35 a |
| Dilution (Folds) | Germination Rates (%) | Mycelial Dry Weight (mg) |
|---|---|---|
| 0 | 1.67 ± 0.52 g | 56.53 ± 2.32 g |
| 2 | 4.83 ± 1.17 f | 77.33 ± 2.06 f |
| 4 | 8.83 ± 0.75 e | 94.40 ± 2.20 e |
| 8 | 15.17 ± 1.94 d | 105.18 ± 3.01 d |
| 16 | 33.17 ± 3.43 c | 115.63 ± 2.65 c |
| 32 | 50.17 ± 4.26 b | 135.43 ± 6.68 b |
| ck | 83.50 ± 3.21 a | 232.92 ± 8.53 a |
Publisher’s Note: MDPI stays neutral with regard to jurisdictional claims in published maps and institutional affiliations. |
© 2022 by the authors. Licensee MDPI, Basel, Switzerland. This article is an open access article distributed under the terms and conditions of the Creative Commons Attribution (CC BY) license (https://creativecommons.org/licenses/by/4.0/).
Share and Cite
Zhu, N.; Zhou, J.-J.; Zhang, S.-W.; Xu, B.-L. Mechanisms of Trichoderma longibrachiatum T6 Fermentation against Valsa mali through Inhibiting Its Growth and Reproduction, Pathogenicity and Gene Expression. J. Fungi 2022, 8, 113. https://doi.org/10.3390/jof8020113
Zhu N, Zhou J-J, Zhang S-W, Xu B-L. Mechanisms of Trichoderma longibrachiatum T6 Fermentation against Valsa mali through Inhibiting Its Growth and Reproduction, Pathogenicity and Gene Expression. Journal of Fungi. 2022; 8(2):113. https://doi.org/10.3390/jof8020113
Chicago/Turabian StyleZhu, Na, Jing-Jiang Zhou, Shu-Wu Zhang, and Bing-Liang Xu. 2022. "Mechanisms of Trichoderma longibrachiatum T6 Fermentation against Valsa mali through Inhibiting Its Growth and Reproduction, Pathogenicity and Gene Expression" Journal of Fungi 8, no. 2: 113. https://doi.org/10.3390/jof8020113
APA StyleZhu, N., Zhou, J.-J., Zhang, S.-W., & Xu, B.-L. (2022). Mechanisms of Trichoderma longibrachiatum T6 Fermentation against Valsa mali through Inhibiting Its Growth and Reproduction, Pathogenicity and Gene Expression. Journal of Fungi, 8(2), 113. https://doi.org/10.3390/jof8020113

